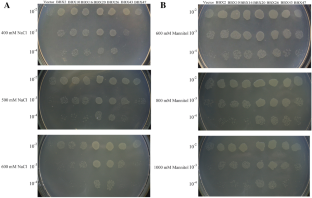

Abstract
The B-box proteins (BBXs) are zinc finger proteins containing one or two B-box domain(s) and involved in regulation of development processes as transcription factors in plants. Here, seven BBX genes in Malus domestica genome (MdBBXs) were identified and found to be up-regulated under abiotic stresses, with 2–12 folds in roots. All recombinant MdBBXs expressed in Escherichia coli (E. coli) enhanced the cell’s tolerance to salt and osmotic stresses, respectively. Deficiency of B-box domain of MdBBX10 led to the loss of anti-stress functions. Five conservative cysteines in B-box domain played crucial roles in stress resistance, which are involved in two of metal iron binding sites of zinc finger motifs in BBXs. All the above results suggested MdBBXs confer stress tolerance to E. coli cell against abiotic stresses.

Similar content being viewed by others
References
Agarwal, M., Hao, Y., Kapoor, A., Dong, C. H., Fujii, H., Zheng, X., et al. (2006). A R2R3 type MYB transcription factor is involved in the cold regulation of CBF genes and in acquired freezing tolerance. Journal of Biological Chemistry, 281(49), 37636–37645.
Bai, S., Saito, T., Honda, C., Hatsuyama, Y., Ito, A., & Moriguchi, T. (2014). An apple B-box protein, MdCOL11, is involved in UV-B- and temperature-induced anthocyanin biosynthesis. Planta, 240(5), 1051–1062. https://doi.org/10.1007/s00425-014-2129-8.
Borden, K. L. (1998). RING fingers and B-boxes: zinc-binding protein–protein interaction domains. Biochemistry and Cell Biology, 76, 351–358.
Chu, Z., Wang, X., Li, Y., Yu, H., Li, J., Lu, Y., et al. (2016). Genomic organization, phylogenetic and expression analysis of the B-box gene family in tomato. Frontiers in plant science, 7, 1552. https://doi.org/10.3389/fpls.2016.01552.
Datta, S., Hettiarachchi, C., Johansson, H., & Holm, M. (2007). SALT TOLERANCE HOMOLOG2, a B-box protein in Arabidopsis that activates transcription and positively regulates light-mediated development. The Plant Cell, 19(10), 3242–3255. https://doi.org/10.1105/tpc.107.054791.
Du, F., Xu, J.-N., Zhan, C.-Y., Yu, Z.-B., & Wang, X.-Y. (2014). An obesity-like gene MdTLP7 from apple (Malus × domestica) enhances abiotic stress tolerance. Biochemical and Biophysical Research Communications, 445(2), 394–397. https://doi.org/10.1016/j.bbrc.2014.02.005.
Eulgem, T., & Somssich, I. E. (2007). Networks of WRKY transcription factors in defense signaling. Current Opinion in Plant Biology, 10(4), 366–371. https://doi.org/10.1016/j.pbi.2007.04.020.
Gangappa, S. N., & Botto, J. F. (2014). The BBX family of plant transcription factors. Trends in Plant Science, 19(7), 460–470. https://doi.org/10.1016/j.tplants.2014.01.010.
Gupta, K., Agarwal, P. K., Reddy, M. K., & Jha, B. (2010). SbDREB2A, an A-2 type DREB transcription factor from extreme halophyte Salicornia brachiata confers abiotic stress tolerance in Escherichia coli. Plant Cell Reports, 29(10), 1131–1137.
Tao, H., Simmons, B. N., Singireddy, S., Jakkidi, M., Short, K. M., et al. (2008). Structure of the MID1 tandem B-boxes reveals an interaction reminiscent of intermolecular ring heterodimers. Biochemistry, 47, 2450–2457.
Huang, J., Zhao, X., Weng, X., Wang, L., & Xie, W. (2012). The rice B-box zinc finger gene family: genomic identification, characterization, expression profiling and diurnal analysis. PLoS ONE, 7(10), e48242. https://doi.org/10.1371/journal.pone.0048242.
Jabeen, B., Naqvi, S. M., Mahmood, T., Sultana, T., Arif, M., & Khan, F. (2017). Ectopic expression of plant RNA chaperone offering multiple stress tolerance in E coli. Molecular Biotechnology, 59(2–3), 66.
Khanna, R., Kronmiller, B., Maszle, D. R., Coupland, G., Holm, M., Mizuno, T., et al. (2009). The Arabidopsis B-box zinc finger family. The Plant Cell, 21(11), 3416–3420. https://doi.org/10.1105/tpc.109.069088.
Gasic, Ksenija, Hernadez, Alvaro, & Korban, S. S. (2004). RNA extraction from different apple tissues rich in polyphenols and polysaccharides for cDNA library construction. Plant Molecular Biology Reporter, 22, 437a–437g.
Liu, X., Li, R., Dai, Y., Chen, X., & Wang, X. (2017). Genome-wide identification and expression analysis of the B-box gene family in the Apple (Malus domestica Borkh.) genome. Molecular Genetics and Genomics, 7(1), 1–13.
Massiah, M. A., Matts, J. A., Short, K. M., Simmons, B. N., Singireddy, S., Yi, Z., et al. (2007). Solution structure of the MID1 B-box2 CHC(D/C)C(2)H(2) zinc-binding domain: insights into an evolutionarily conserved RING fold. Journal of Molecular Biology, 369(1), 1–10.
Min, J. H., Chung, J. S., Lee, K. H., & Kim, C. S. (2015). The CONSTANS-like 4 transcription factor, AtCOL4, positively regulates abiotic stress tolerance through an abscisic acid-dependent manner in Arabidopsis. Journal of Integrative Plant Biology, 57(3), 313–324. https://doi.org/10.1111/jipb.12246.
Nagaoka, S., & Takano, T. (2003). Salt tolerance-related protein STO binds to a Myb transcription factor homologue and confers salt tolerance in Arabidopsis. Journal of Experimental Botany, 54(391), 2231–2237.
Nakashima, K., & Yamaguchi-Shinozaki, K. (2009). Transcriptional regulatory networks in response to abiotic stresses in Arabidopsis and grasses. Plant Physiology, 149(1), 88.
Qi, Q., Gibson, A., Fu, X., Zheng, M., Kuehn, R., Wang, Y., et al. (2012). Involvement of the N-terminal B-box domain of arabidopsis BBX32 protein in interaction with soybean BBX62 protein. Journal of Biological Chemistry, 287(37), 31482.
Singh, K., Foley, R. C., & Onate-Sanchez, L. (2002). Transcription factors in plant defense and stress responses. Current Opinion in Plant Biology, 5(5), 430–436. https://doi.org/10.1016/s1369-5266(02)00289-3.
Su, H., Zhang, S., Yuan, X., Chen, C., Wang, X.-F., & Hao, Y.-J. (2013). Genome-wide analysis and identification of stress-responsive genes of the NAM–ATAF1,2–CUC2 transcription factor family in apple. Plant Physiology and Biochemistry, 71, 11–21. https://doi.org/10.1016/j.plaphy.2013.06.022.
Talar, U., Kielbowicz-Matuk, A., Czarnecka, J., & Rorat, T. (2017). Genome-wide survey of B-box proteins in potato (Solanum tuberosum)-Identification, characterization and expression patterns during diurnal cycle, etiolation and de-etiolation. PLoS ONE, 12(5), e0177471. https://doi.org/10.1371/journal.pone.0177471.
Torok, M., & Etkin, L. D. (2001). Two B or not two B? Overview of the rapidly expanding B-box family of proteins. Differentiation, 67, 63–71.
Xu, D., Jiang, Y., Li, J., Holm, M., & Deng, X. (2017). The B-box domain protein BBX21 promotes photomorphogenesis. Plant Physiology, 176, 2365.
Xu, J. N., Xing, S. S., Zhang, Z. R., Chen, X. S., & Wang, X. Y. (2016). Genome-wide identification and expression analysis of the tubby-like protein family in the malus domestica genome. Frontiers in Plant Science, 7, 1693. https://doi.org/10.3389/fpls.2016.01693.
Yuan, H., Zhao, K., Lei, H., Shen, X., Liu, Y., Liao, X., et al. (2013). Genome-wide analysis of the GH3 family in apple (Malus × domestica). BMC Genomics, 14(1), 297. https://doi.org/10.1186/1471-2164-14-297.
Zhao, J., Guo, R., Guo, C., Hou, H., Wang, X., & Gao, H. (2016). Evolutionary and expression analyses of the apple basic leucine zipper transcription factor family. Frontiers in Plant Science, 7, 376. https://doi.org/10.3389/fpls.2016.00376.
Zou, Z., Wang, R., Wang, R., Yang, S., & Yang, Y. (2017). Genome-wide identification, phylogenetic analysis, and expression profiling of the BBX family genes in pear. The Journal of Horticultural Science & Biotechnology. https://doi.org/10.1080/14620316.2017.1338927.
Acknowledgements
This work was supported by Special Research Fund of Public Welfare of China Agricultural Ministry (201303093).
Author information
Authors and Affiliations
Contributions
Designed the experiments: XYW and XL. Performed the experiments: XL, YQD, RL, and LY. Analyzed the data: XL, YQD, and XSC. Wrote the paper: XYW and XL. All authors read and approved the manuscript.
Corresponding author
Ethics declarations
Conflict of interest
The authors declare no conflicts of interests.
Additional information
Publisher's Note
Springer Nature remains neutral with regard to jurisdictional claims in published maps and institutional affiliations.
Electronic supplementary material
Below is the link to the electronic supplementary material.
Rights and permissions
About this article
Cite this article
Liu, X., Dai, Y., Li, R. et al. Members of B-box Protein Family from Malus domestica Enhanced Abiotic Stresses Tolerance in Escherichia coli. Mol Biotechnol 61, 421–426 (2019). https://doi.org/10.1007/s12033-019-00172-8
Published:
Issue Date:
DOI: https://doi.org/10.1007/s12033-019-00172-8




